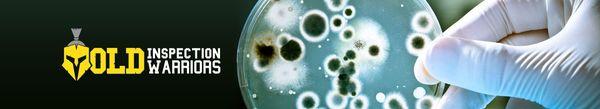
Mold Inspection Warriors

Nexthb
840 Hinckley Rd
Burlingame, CA 94010
Nexthb is a technology company based in Burlingame, CA, specializing in software development and digital solutions.
With a focus on innovation and efficiency, Nexthb offers custom software development services to meet the unique needs of businesses across various industries.
Generated from their business information
Also at this address
See a problem?
You might also like
Partial Data by Infogroup (c) 2024. All rights reserved.